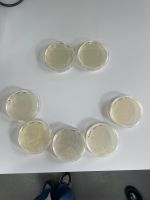

Our Team

Livia Del Bo
Role: Team Leader
Degree: BSc Biological Sciences (Biotechnology)
Year: 4th year
Favourite iDEC Memory: Team Potluck.

Cecilia Barcia Pintado
Role: Team Member
Degree: BSc Biological Sciences (Biochemistry)
Year: 4th year
Favourite iDEC Memory: discovering that a syringe can make the purification step a little more bearable.

Kimberly Littler
Role: Team Member
Degree: BSc Biological Sciences (Genetics)
Year: 4th year
Favourite iDEC Memory: The smell of the media kitchen.

Pimvalan Petchmunee
Role: Team Member
Degree: BSc Biological Sciences (Biotechnology)
Year: 4th year
Favourite iDEC Memory: Team Potluck. It was so good it had to be mentioned twice.

Rikuo Miyamoto
Role: Team Member
Degree: BSc Biological Sciences (Biotechnology)
Year: 4th year
Favourite iDEC Memory: the hours spent with Obi-Wan and Yoda (the PCR machines).
Our Supervisors
Heather Barker, Joanna Sadler, Chris French, and Nadanai Laohakunakorn